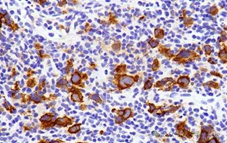
image.png

简单介绍几句话简单介绍几句话

免疫组化
免疫组化,是应用免疫学基本原理——抗原抗体反应,即抗原与抗体特异性结合的原理,通过化学反应使标记抗体的显色剂(荧光素、酶、金属离子、同位素)显色来确定组织细胞内抗原(多肽和蛋白质),对其进行定位、定性及定量的研究,称为免疫组织化学技术(immunohistochemistry)或免疫细胞化学技术(immunocytochemistry)。
1. 免疫组化
2. 免疫组化(组织芯片)
3. 免疫组化(大组织)
4. 细胞芯片ICC+扫描分析
5. 组化封片
6. 组化制片(滴片/涂片)

免疫荧光
免疫荧光标记即利用抗原抗体特异性结合原理,在同一张切片上多个抗原进行同时标记,从而实现定位,定性,半定量的分析。
1. 免疫荧光单标双色(切片)
2. 免疫荧光双标三色(切片)
3. 免疫荧光三标四色(切片)
4. 免疫荧光四标五色(切片)
5. 免疫荧光五标六色(切片)
6. 免疫荧光六标七色(切片)
7. 免疫荧光单标双色(芯片)
8. 免疫荧光双标三色(芯片)
9. 免疫荧光三标四色(芯片)
10. 免疫荧光四标五色(芯片)
11. 免疫荧光五标六色(芯片)
12. 免疫荧光六标七色(芯片)
13. 染色
14. 荧光封片/制片


TUNEL
基因组DNA断裂时,暴露的3’-OH可以在末端脱氧核苷酸转移酶(Terminal Deoxynucleotidyl Transferase, TdT) 的催化下加上荧光素 (FITC) 标记的dUTP (fluorescein-dUTP) ,从而可以通过荧光显微镜或流式细胞仪进行检测,这就是TUNEL (TdT-mediated dUTP Nick-End Labeling) 法检测细胞凋亡的原理。
1. TUNEL(白光)检测
2. TUNEL(荧光)检测
3. TUNEL(组织芯片)检测
4. TUNEL(细胞芯片)检测
5. IF TUNEL双染检测


原位杂交
原位杂交原理:原位杂交是指将特定标记的已知序列核酸为探针与细胞或组织切片中核酸进行杂交,从而对特定核酸顺序进行精确定量定位的过程。原位杂交可以在细胞标本或组织标本上进行。
1. 原位杂交(DAB)
2. 原位杂交(BCIP/NBT)
3. 原位杂交(FISH单标)
4. 原位杂交(FISH、IF双染)
5. 原位杂交(FISH双标/三标)
6. 原位杂交(组织芯片)
7. 原位杂交(FISH、IF、IF三染)
8. 原位杂交制片(滴片/涂片)



扫一扫关注微信